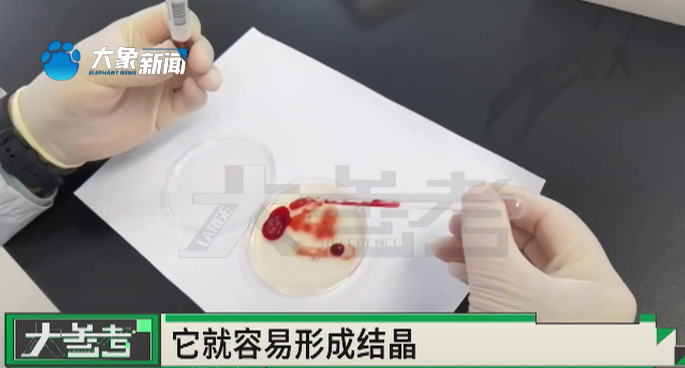

近日,河南驻马店一60岁男子劳作后
误喝下500毫升汽车防冻液



11小时后才就医
在驻马店市中心医院妇女儿童医院抢救




就医时血液已凝固如胶冻
最终,该男子因肝肾衰竭
治疗无效不幸去世


据郑州大学附属郑州中心医院急诊科
主治医师顿少志介绍
据悉,目前市面上
绝大多数防冻液主要成分是乙二醇






农忙季节
大家一定要注意
尽量使用专门的水具喝水
下田之前
提前准备好足量的食物和水
生命诚可贵!
千万不可大意!
来 源:河南广播电视台民生频道“民生大参考”、大象新闻客户端
近日,河南驻马店一60岁男子劳作后
误喝下500毫升汽车防冻液



11小时后才就医
在驻马店市中心医院妇女儿童医院抢救




就医时血液已凝固如胶冻
最终,该男子因肝肾衰竭
治疗无效不幸去世

据郑州大学附属郑州中心医院急诊科
主治医师顿少志介绍
据悉,目前市面上
绝大多数防冻液主要成分是乙二醇






农忙季节
大家一定要注意
尽量使用专门的水具喝水
下田之前
提前准备好足量的食物和水
生命诚可贵!
千万不可大意!
来 源:河南广播电视台民生频道“民生大参考”、大象新闻客户端